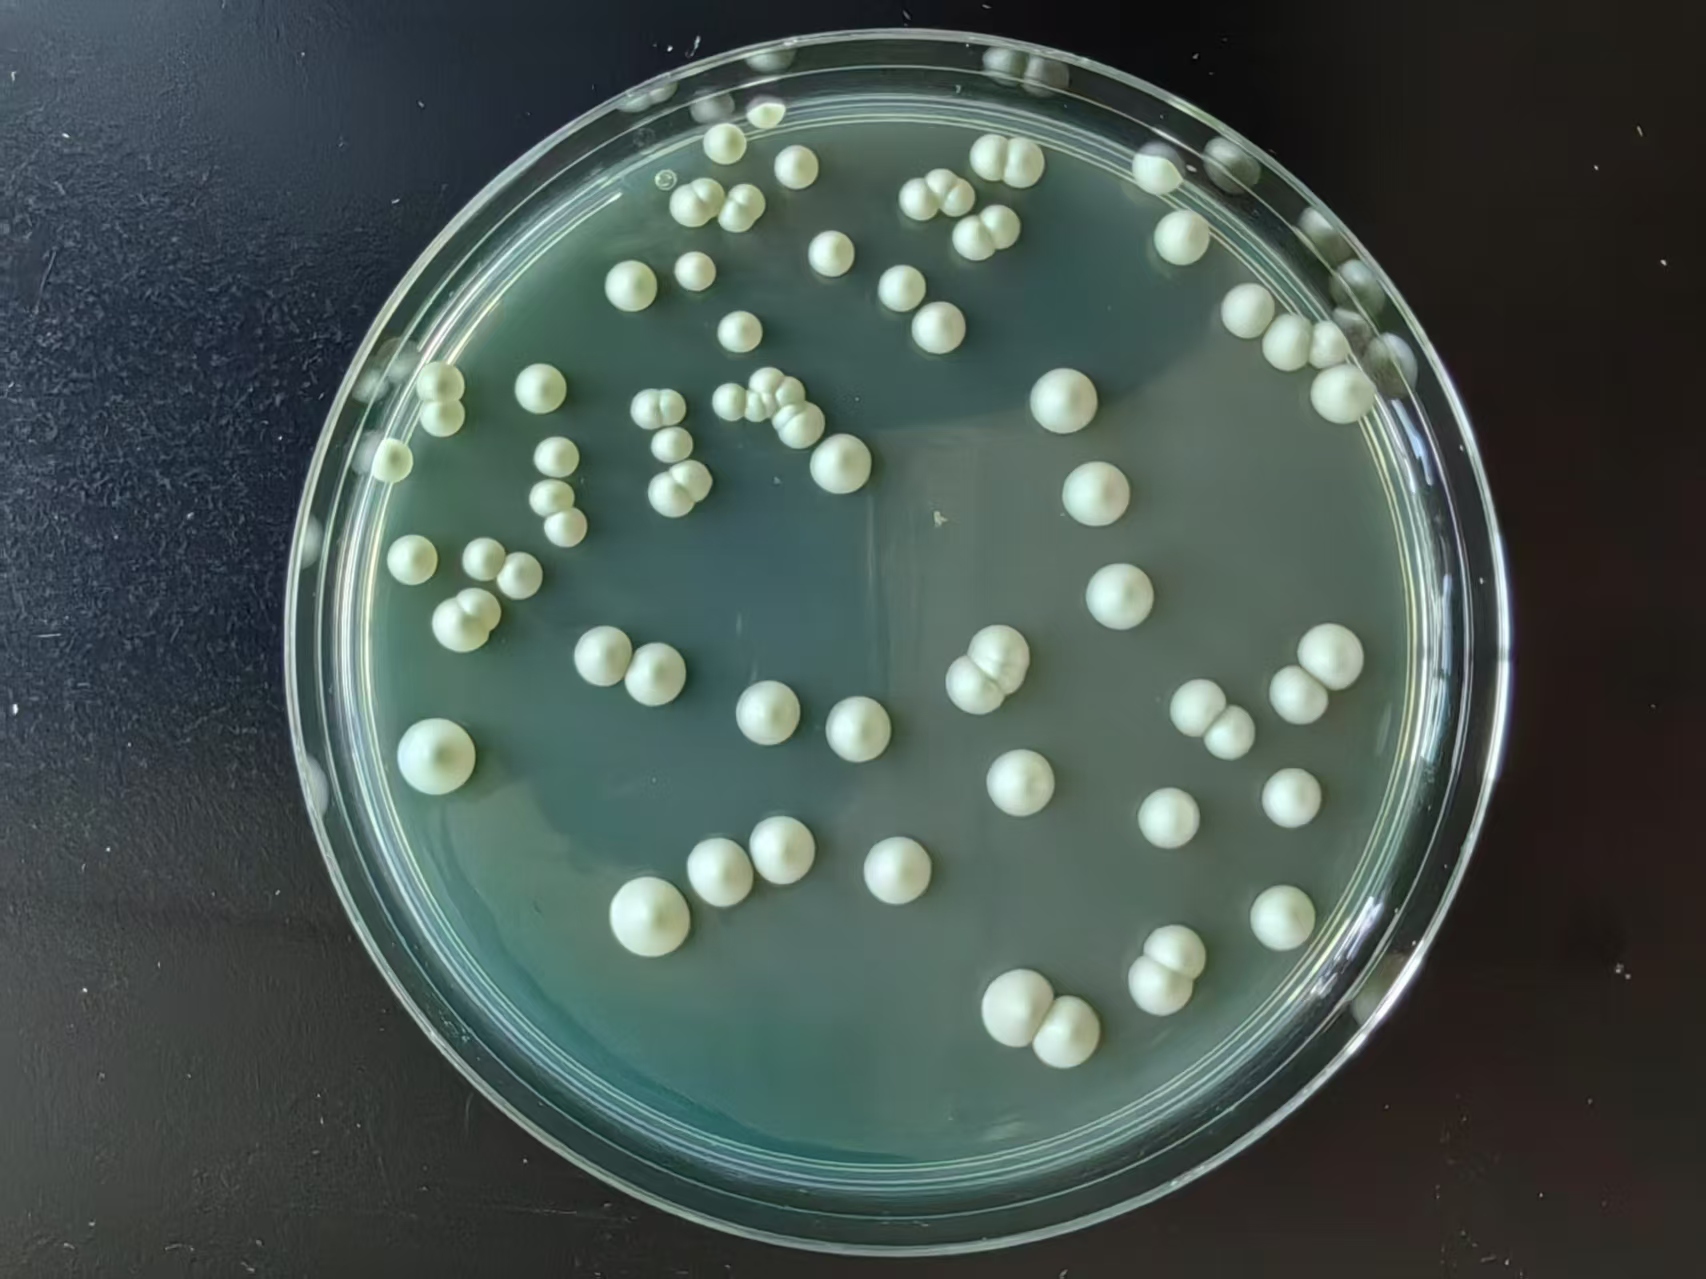

国产首款!西农科学家育成的干白葡萄酒酵母量产应用
记者从西北农林科技大学获悉,5月下旬,由国家葡萄产业技术体系酿酒微生物岗位科学家、西北农林科技大学葡萄酒学院刘延琳教授团队历时17年育成的国内首株干白葡萄酒本土酿酒酵母NX16菌株实现产业化并成功量产,截至目前已在东欧酿造了500余吨干白葡萄酒。

葡萄酒酵母
这也是该团队继2013年率先实现两株干红葡萄酒本土酵母CECA和CEC01产业化应用,实现本土葡萄酒酵母产业化研发“从0到1”的突破后,选育并产业化的第3株本土酿酒酵母菌株。
微生物是国家战略性生物资源之一,葡萄酒酵母是葡萄酒产业的“微生物种子”,但葡萄酒酵母技术长期被国外垄断,开启中国葡萄酒本土微生物“风土”研究对突破技术隐患和产业风险有重大意义。
记者了解到,2000年以来,在国家相关项目支持下,刘延琳团队首次系统完成了我国葡萄酒主产区酵母种质资源收集、整理与研究,建成保存有2万余株酵母的种质资源库,获得了316种基因型的酿酒酵母核心种质,为本土酵母的开发与应用奠定了坚实基础。
酵母
“产业需求是我们研发的导向。”刘延琳介绍,干白葡萄酒是全球酒类市场的重要组成部分,近年来,消费者更加注重健康的生活方式,低酒精度、无糖的干白葡萄酒以其清爽的口感和多样化的风味逐渐成为市场的新宠。为此,通过精确控制发酵过程来提升酒品的质量与稳定性迫在眉睫。
为了找到适合中国风味的干白葡萄酒酵母,2007年起,刘延琳团队在宁夏御马酒庄葡萄园采集了上千株酵母资源,经过菌株抗逆性与酿酒特性研究、菌株发酵初筛、小容器酿酒试验复筛、中试验证到大生产试验,并在新疆、宁夏贺兰山东麓、环渤海湾等葡萄酒产区的多家企业开展了8年以上的中试和大生产示范应用,育成国内首株干白葡萄酒本土酿酒酵母NX16菌株。今年全球第二大酵母公司安琪酵母股份有限公司对NX16酵母开展了市场化推广。
“使用“NX16”酵母酿造的霞多丽葡萄酒酒体晶莹透亮,洋槐花、金合欢花的花香与橙子、柚子、菠萝的果香完美融合,清爽活泼,浓郁丰富。”御马酒庄技术总监白稳红表示。
“目前,我们已经选育出29株酿酒功能细分的优良本土酵母菌株,后续将继续通过与企业产学研紧密合作,不断突出具有中国特色的本土酵母,不仅提升中国葡萄酒整体质量方面,更期望本土酵母在多样化、个性化表达方面奉献独特的‘微生物风土’,实现‘中国风土,世界品质’。”对此,刘延琳充满信心。
编辑:陕西农村广播



热门评论
打开“起点新闻”查看更多热评